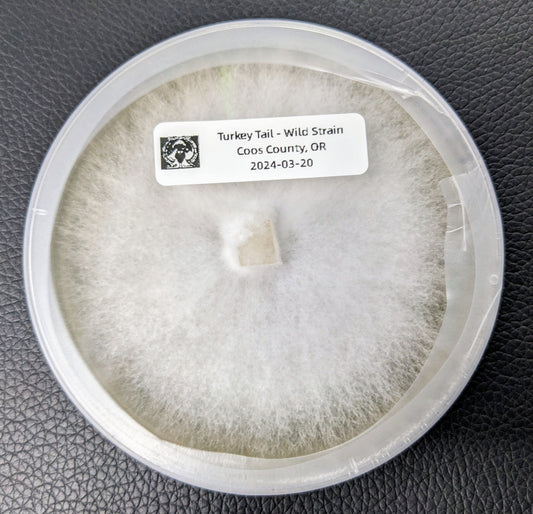

Collection: Agar Plates
-
Sold outSmith River Reishi - Agar plate
Regular price $15.00 USDRegular priceUnit price / per$15.00 USDSale price $15.00 USDSold out -
Sold outSunset Bay Oyster - Agar plate
Regular price $15.00 USDRegular priceUnit price / per$15.00 USDSale price $15.00 USDSold out -
South Slough Turkey Tail - Agar Plate
Regular price $15.00 USDRegular priceUnit price / per$15.00 USDSale price $15.00 USDSold out